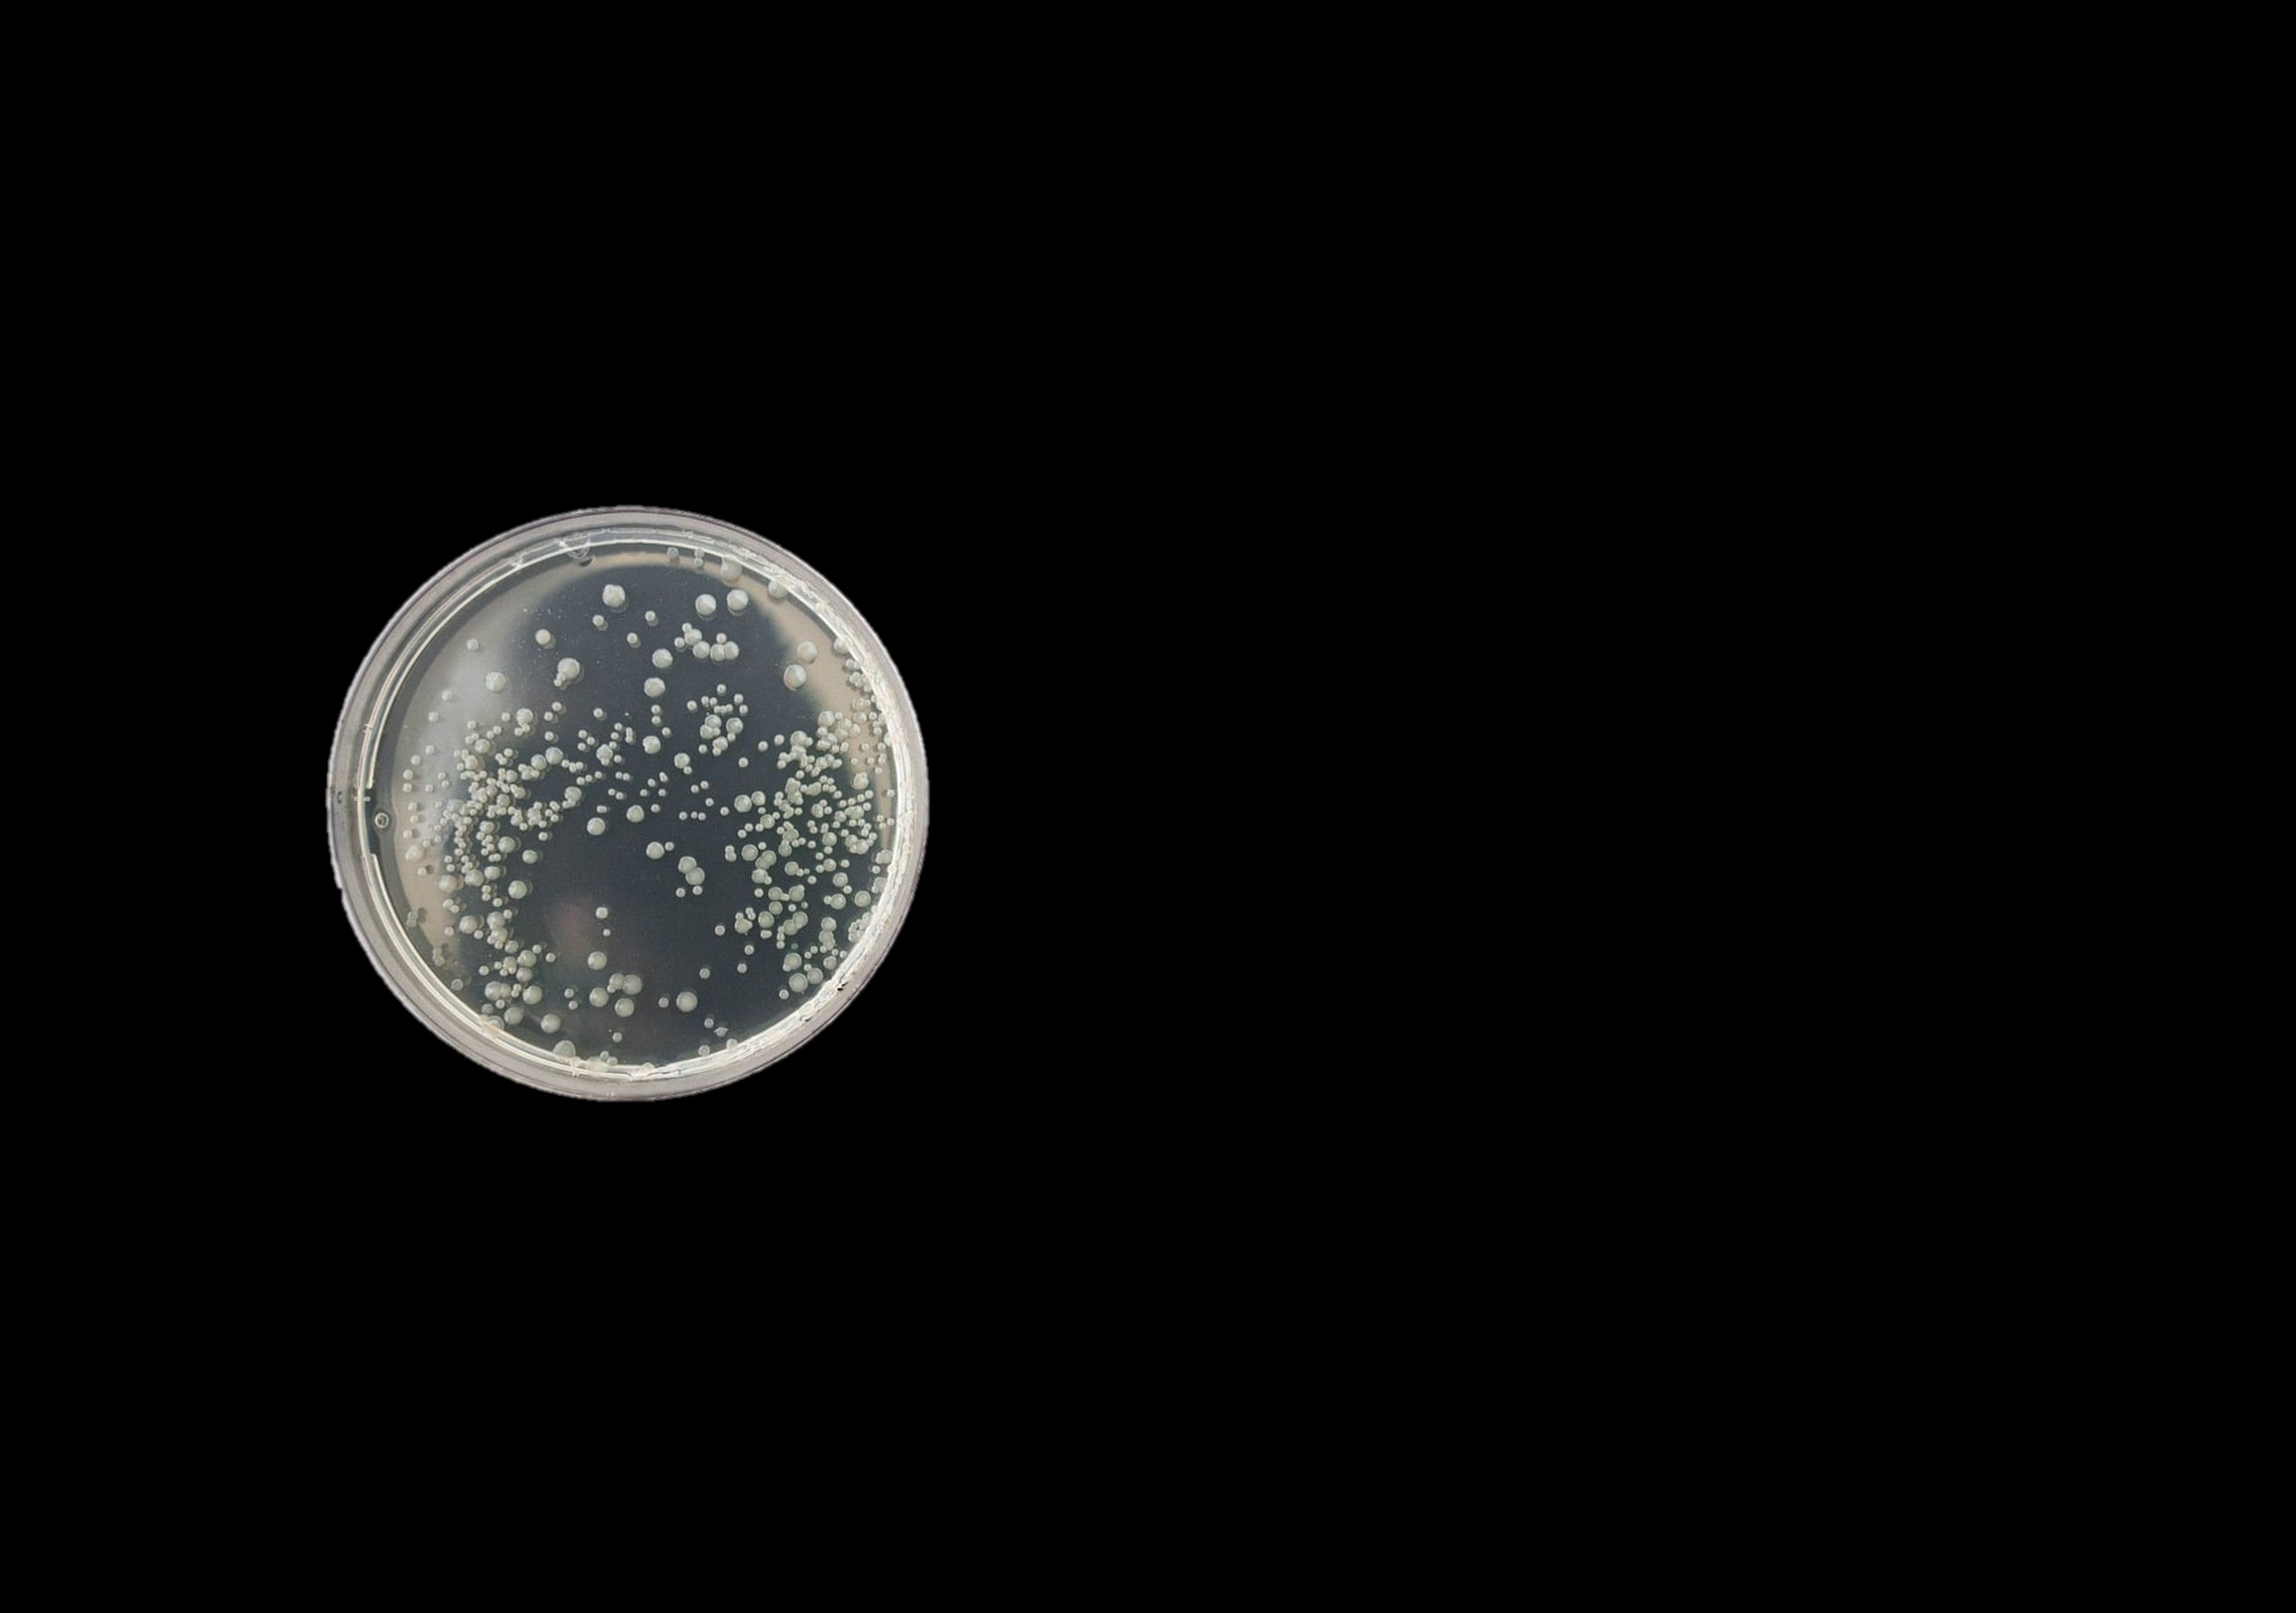

The Fowler lab studies bacterial evolution and how bacterial pathogens cause disease. We are broadly interested in these topics, but much of our research focuses on the globally-important pathogen Salmonella enterica, particularly the human-adapted serovar Salmonella Typhi.
Some topics of special interest to our lab include:
⦿ Salmonella pathogenesis
⦿ Dissecting the differences between different Salmonella species/serovars/strains
⦿ Bacterial toxins
⦿ How bacteria evolve to sense and respond to new niches
⦿ Two-component regulatory systems
⦿ The application of bacteria or bacterial products for biomedical of industrial applications
